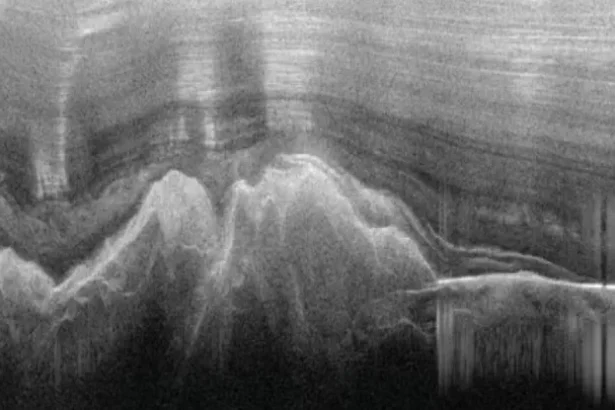
Antarctica's Gamburtsev Mountains covered by ice, discovered using sound waves in 1958.

Wednesday, May 13, 2026
Explore by Topics
Subscribe
HIDDEN MOUNTAINS
Hidden Antarctic Mountains Discovered Under Ice, Similar to Alps!
Discover the hidden Gamburtsev Mountains buried under Antarctica's ice, as big as Europe's Alps, and over 650 million years old!
The Daily Newsletter
Brings you a selection of the latest news, trends, insights, and tips from around the world.